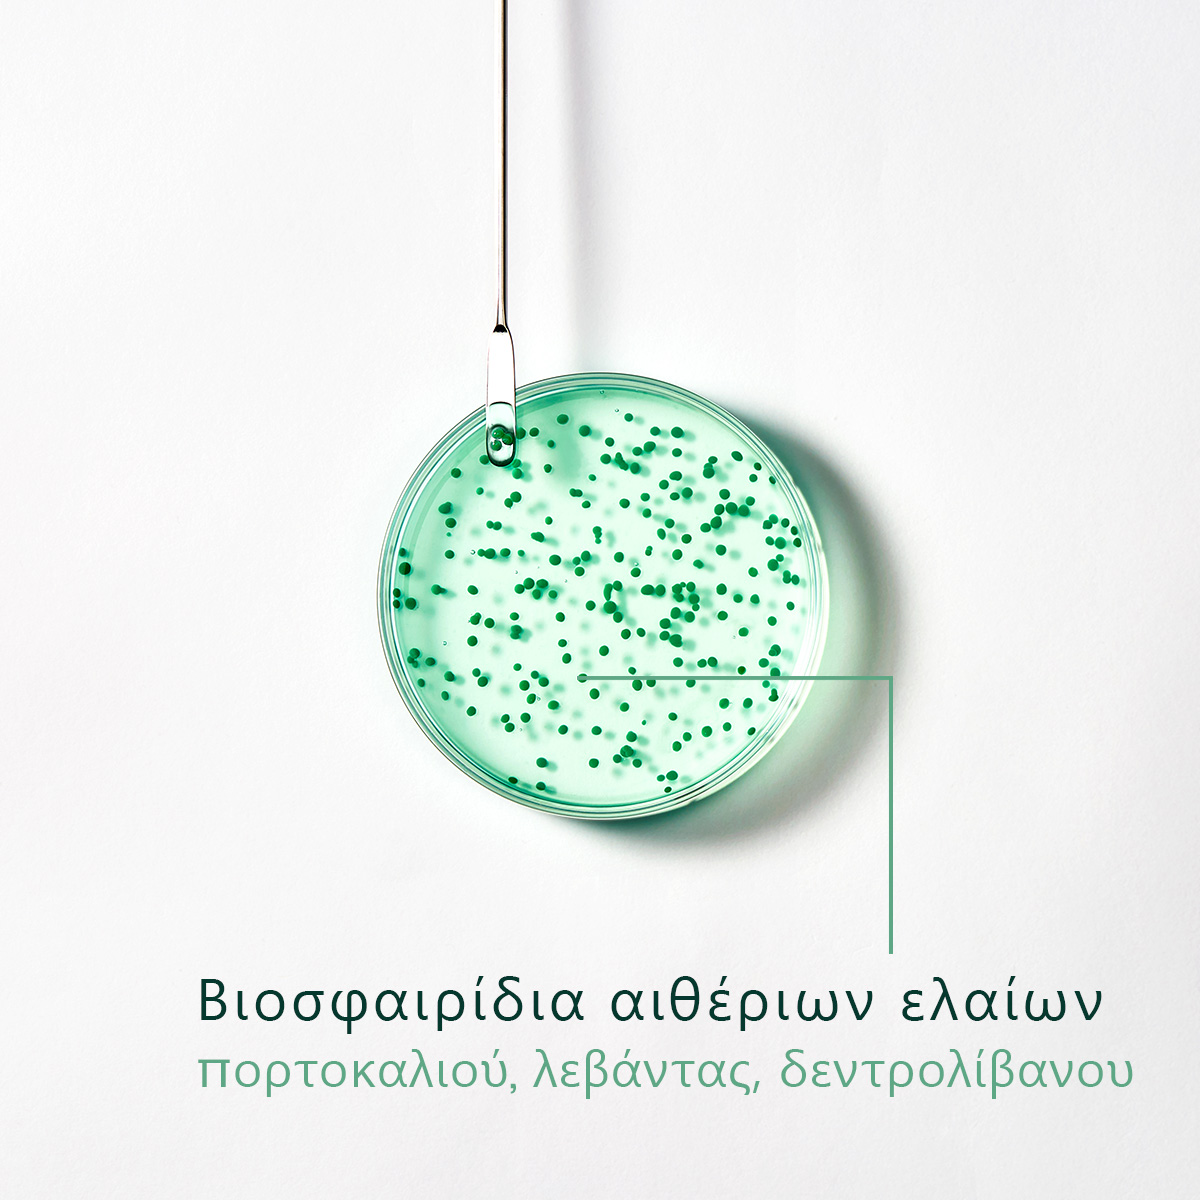

RENE FURTERER - FORTICEA Shampooing Energisant - 250ml
Τόνωση & δράση κατά της τριχόπτωσης (Energizing Shampoo)
Το τονωτικό σαμπουάν Forticea Shampooing Energisant της Rene Furterer έχει δράση κατά της τριχόπτωσης.
Χάρη στη συνδυαστική δράση των αιθέριων ελαίων και του φυτικού εκχυλίσματος Pfaffia που περιέχει, το Rene Furterer Forticea Shampooing Energisant διεγείρει τη μικροκυκλοφορία του τριχωτού και χαρίζει στην τρίχα δύναμη και λάμψη.
Κύρια συστατικά & οφέλη
Εκχύλισμα Pfaffia: προερχόμενο από το τροπικό δάσος του Αμαζονίου, το Pfaffia ή το Βραζιλιάνικο Ginseng είναι ένα από τα πιο γνωστά φυτά στην παραδοσιακή ιατρική. Αυτό το δραστικό συστατικό με ασυναγώνιστη ισχύ, μεγιστοποιεί την παροχή βασικών συστατικών στα μαλλιά, ενεργοποιώντας τον αυξητικό παράγοντα VEGF που βελτιώνει την μικροκυκλοφορία, διεγείροντας έτσι την ανάπτυξη.
Αιθέριο έλαιο πορτοκάλι: εισαγόμενο από τους πρόποδες των Ιμαλαΐων από πορτογάλους εξερευνητές, το γλυκό πορτοκάλι ήταν φρούτο πολυτελείας μέχρι το πρώτο μισό του 20ού αιώνα. Το αιθέριο έλαιο που εξάγεται από τη φλούδα του είναι γνωστό για το ελαφρύ άρωμα και τις καταπραϋντικές του ιδιότητες, αλλά είναι επίσης ένα αποτελεσματικό καθαριστικό και τονωτικό συστατικό για τη μικροκυκλοφορία.
Αιθέριο έλαιο λεβάντα: η λεβάντα ανακαλύφθηκε στην Περσία. Με το μοναδικό άρωμά του, αυτό το μικρό γαλαζοπράσινο λουλούδι χρησιμοποιήθηκε από τους Ρωμαίους για χαλάρωση και για άρωμα των λουτρών τους. Το πολύτιμο αιθέριο έλαιο που λαμβάνεται από την απόσταξη είναι γνωστό για τις αντισηπτικές και χαλαρωτικές του ιδιότητες.
Αιθέριο έλαιο δενδρολίβανο: το δενδρολίβανο, ή η «δροσιά της θάλασσας» στα λατινικά, φύεται γύρω από τη λεκάνη της Μεσογείου. Το αιθέριο έλαιό του έχει τονωτικές ιδιότητες και διεγείρει τη μικροκυκλοφορία για την καταπολέμηση της τριχόπτωσης. Οι καθαριστικές του ιδιότητες το καθιστούν επίσης ένα αποτελεσματικό φυσικό φάρμακο για την πιτυρίδα.
Αποτελεσματικότητα χρήσης του Rene Furterer Forticea Shampooing Energisant
Πεπεισμένοι καταναλωτές 96% (δοκιμή που πραγματοποιήθηκε για 3 εβδομάδες σε 78 άνδρες).
Ανθεκτικά μαλλιά 92% (δοκιμή που πραγματοποιήθηκε σε 74 άνδρες, αποτελέσματα μετά από 3 εβδομάδες χρήσης).
Μαλλιά με ενέργεια 92% (δοκιμή που πραγματοποιήθηκε σε 74 άνδρες, αποτελέσματα μετά από 3 εβδομάδες χρήσης).
Μαλλιά πιο ανάλαφρα 92% (δοκιμή σε 74 άνδρες).
Με το Rene Furterer Forticea Shampooing Energisant τα μαλλιά αποκτούν πάλι δύναμη και λάμψη
Βασικά χαρακτηριστικά
Με υφή gel.
Χωρίς σιλικόνη.
ΣΥΜΒΟΥΛΕΣ ΕΦΑΡΜΟΓΗΣ
Εφαρμόστε το Rene Furterer Forticea Shampooing Energisant σε νωπό τριχωτό.
Δημιουργήστε αφρό και κάντε απαλό μασάζ με κυκλικές κινήσεις από τον αυχένα έως την κορυφή του κεφαλιού.
Αφήστε να δράσει για 1-3'.
Ξεπλύντε με άφθονο νερό.

Δεν έχει προστεθεί κάποια αξιολόγηση ακόμα.
*Η διαθεσιμότητα καθώς και η τελική τιμή του προϊόντος ενδέχεται να διαφοροποιούνται στα φαρμακεία μας.
Προσφορές
210 3005 295

engine 


Τόνωση & δράση κατά της τριχόπτωσης (Energizing Shampoo)
Το τονωτικό σαμπουάν Forticea Shampooing Energisant της Rene Furterer έχει δράση κατά της τριχόπτωσης.
Χάρη στη συνδυαστική δράση των αιθέριων ελαίων και του φυτικού εκχυλίσματος Pfaffia που περιέχει, το Rene Furterer Forticea Shampooing Energisant διεγείρει τη μικροκυκλοφορία του τριχωτού και χαρίζει στην τρίχα δύναμη και λάμψη.
Κύρια συστατικά & οφέλη
Εκχύλισμα Pfaffia: προερχόμενο από το τροπικό δάσος του Αμαζονίου, το Pfaffia ή το Βραζιλιάνικο Ginseng είναι ένα από τα πιο γνωστά φυτά στην παραδοσιακή ιατρική. Αυτό το δραστικό συστατικό με ασυναγώνιστη ισχύ, μεγιστοποιεί την παροχή βασικών συστατικών στα μαλλιά, ενεργοποιώντας τον αυξητικό παράγοντα VEGF που βελτιώνει την μικροκυκλοφορία, διεγείροντας έτσι την ανάπτυξη.
Αιθέριο έλαιο πορτοκάλι: εισαγόμενο από τους πρόποδες των Ιμαλαΐων από πορτογάλους εξερευνητές, το γλυκό πορτοκάλι ήταν φρούτο πολυτελείας μέχρι το πρώτο μισό του 20ού αιώνα. Το αιθέριο έλαιο που εξάγεται από τη φλούδα του είναι γνωστό για το ελαφρύ άρωμα και τις καταπραϋντικές του ιδιότητες, αλλά είναι επίσης ένα αποτελεσματικό καθαριστικό και τονωτικό συστατικό για τη μικροκυκλοφορία.
Αιθέριο έλαιο λεβάντα: η λεβάντα ανακαλύφθηκε στην Περσία. Με το μοναδικό άρωμά του, αυτό το μικρό γαλαζοπράσινο λουλούδι χρησιμοποιήθηκε από τους Ρωμαίους για χαλάρωση και για άρωμα των λουτρών τους. Το πολύτιμο αιθέριο έλαιο που λαμβάνεται από την απόσταξη είναι γνωστό για τις αντισηπτικές και χαλαρωτικές του ιδιότητες.
Αιθέριο έλαιο δενδρολίβανο: το δενδρολίβανο, ή η «δροσιά της θάλασσας» στα λατινικά, φύεται γύρω από τη λεκάνη της Μεσογείου. Το αιθέριο έλαιό του έχει τονωτικές ιδιότητες και διεγείρει τη μικροκυκλοφορία για την καταπολέμηση της τριχόπτωσης. Οι καθαριστικές του ιδιότητες το καθιστούν επίσης ένα αποτελεσματικό φυσικό φάρμακο για την πιτυρίδα.
Αποτελεσματικότητα χρήσης του Rene Furterer Forticea Shampooing Energisant
Πεπεισμένοι καταναλωτές 96% (δοκιμή που πραγματοποιήθηκε για 3 εβδομάδες σε 78 άνδρες).
Ανθεκτικά μαλλιά 92% (δοκιμή που πραγματοποιήθηκε σε 74 άνδρες, αποτελέσματα μετά από 3 εβδομάδες χρήσης).
Μαλλιά με ενέργεια 92% (δοκιμή που πραγματοποιήθηκε σε 74 άνδρες, αποτελέσματα μετά από 3 εβδομάδες χρήσης).
Μαλλιά πιο ανάλαφρα 92% (δοκιμή σε 74 άνδρες).
Με το Rene Furterer Forticea Shampooing Energisant τα μαλλιά αποκτούν πάλι δύναμη και λάμψη
Βασικά χαρακτηριστικά
Με υφή gel.
Χωρίς σιλικόνη.
ΣΥΜΒΟΥΛΕΣ ΕΦΑΡΜΟΓΗΣ
Εφαρμόστε το Rene Furterer Forticea Shampooing Energisant σε νωπό τριχωτό.
Δημιουργήστε αφρό και κάντε απαλό μασάζ με κυκλικές κινήσεις από τον αυχένα έως την κορυφή του κεφαλιού.
Αφήστε να δράσει για 1-3'.
Ξεπλύντε με άφθονο νερό.